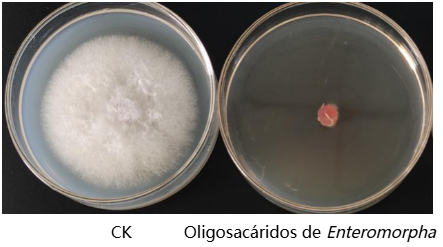
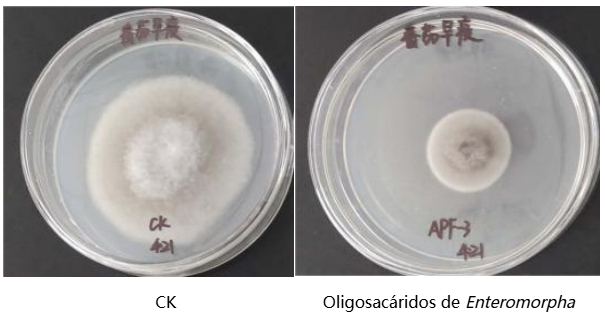

Las pérdidas mundiales anuales de cultivos causadas por enfermedades alcanzan entre el 20% y el 40%. La dependencia excesiva de pesticidas químicos no solo acelera la resistencia de los patógenos, sino que también conduce a la contaminación ambiental y riesgos para la seguridad alimentaria. Por lo tanto, el desarrollo de inductores de inmunidad vegetal verdes y eficientes, así como fungicidas biobasados, se ha convertido en una necesidad urgente para la agricultura sostenible.
Como empresa líder en el desarrollo de sustancias bioactivas marinas, el Grupo Seawin Biotech aprovecha su banco de recursos germinativos de algas verdes controlado de forma independiente para romper la competencia homogénea que ha limitado durante mucho tiempo a los productos convencionales de oligosacáridos. A través de sus propias tecnologías patentadas de hidrólisis enzimática dirigida, la empresa ha sido pionera en lograr la producción a gran escala y precisa de oligosacáridos de algas verdes. En comparación con los oligosacáridos comúnmente disponibles en el mercado, los oligosacáridos de algas verdes exhiben una actividad biológica distintiva en la activación de la inmunidad vegetal y la supresión coordinada de patógenos, gracias a sus estructuras de espina dorsal únicas y diversas, así como a modificaciones naturales de sulfatación.
Esta serie de artículos analizará sistemáticamente el mecanismo natural de resistencia a enfermedades de los oligosacáridos de algas verdes y explorará los factores clave en su transición desde el laboratorio hasta el campo.
Características estructurales de los oligosacáridos de algas verdes
Los oligosacáridos de algas verdes son fragmentos moleculares con un grado de polimerización (DP) de 2 a 20, obtenidos mediante hidrólisis enzimática o degradación química de polisacáridos derivados de algas verdes (como Ulva, Enteromorpha y Chaetomorpha).
Sus características estructurales core incluyen:
Diversidad de espina dorsal: Según su origen biológico, los oligosacáridos de algas verdes incluyen principalmente α-1,3-ramno-oligosacáridos (productos de degradación de polisacáridos de la matriz intercelular de Enteromorpha), β-1,4-mano-oligosacáridos (derivados de polisacáridos de la pared celular de Chaetomorpha), así como oligosacáridos de enlace mixto compuestos por unidades de ácido glucurónico-xilosa-ramnosa y xilosa-galactosa-arabinosa.
Grupos funcionales ricos: Los oligosacáridos de algas verdes portan naturalmente abundantes grupos hidroxilo, grupos carboxilo (de unidades de ácido urónico) y grupos éster sulfático (como sulfatos de ramno-oligosacáridos), lo que les confiere una fuerte hidrofilia y alta reactividad química.
Peso molecular controlado con precisión: Mediante el uso de enzimas específicas que escinden enlaces glicosídicos y otras tecnologías de hidrólisis enzimática dirigida, los polisacáridos de algas verdes pueden convertirse de forma direccional en fracciones de oligosacáridos bioactivos con grados de polimerización definidos.
Los oligosacáridos de algas verdes exhiben actividad dual de resistencia a enfermedades: la combinación sinérgica de activación de inmunidad y acción antimicrobiana dirigida.
1. Actividad inductora de inmunidad vegetal
Los oligosacáridos de algas verdes actúan como patrones moleculares asociados a patógenos (PAMPs, por sus siglas en inglés). Son reconocidos específicamente por receptores de reconocimiento de patrones (PRRs, por sus siglas en inglés) en la membrana celular vegetal, desencadenando así una cascada de respuestas inmunológicas:
(1) Eventos de señalización temprana
① Estallido de señalización de iones de calcio (Ca²⁺)
② Estallido de especies reactivas de oxígeno (ROS, por sus siglas en inglés)
③ Cascadas de fosforilación de cinasas activadas por mitógenos (MAPK, por sus siglas en inglés) (como MPK3/MPK6)
(2) Regulación de la expresión de genes de defensa
① Vía del ácido salicílico (SA, por sus siglas en inglés): Regula positivamente la expresión de proteínas relacionadas con patógenos PR1 y PR2 (β-1,3-glucanasa), induciendo así resistencia adquirida sistémica (SAR, por sus siglas en inglés).
② Vía del ácido jasmónico (JA, por sus siglas en inglés) / etileno (ET, por sus siglas en inglés): Mejora la expresión de genes como inhibidores de proteasas (PI-II), fortaleciendo la resistencia contra insectos masticadores y patógenos necrotróficos.
③ Vía metabólica de fenilpropanoides: Promueve la actividad de enzimas relacionadas con la biosíntesis de lignina (como PAL y 4CL), conduciendo al engrosamiento de la pared celular.
2. Actividad antimicrobiana
Los oligosacáridos de algas verdes ejercen efectos inhibitorios directos contra una amplia gama de patógenos vegetales, y su eficacia antimicrobiana surge de múltiples mecanismos complementarios:
(1) Disrupción física:
Los oligosacáridos carboxilados cargados negativamente se adsorben en la superficie celular microbiana a través de interacciones electrostáticas, alterando así la permeabilidad de la membrana.
(2) Interferencia metabólica:
Los oligosacáridos sulfatados inhiben competitivamente la actividad de la quitina sintasa fúngica.
(3) Inhibición de la percepción de quórum:
Los oligosacáridos de algas verdes con grados de polimerización y características estructurales específicas pueden interferir con la transmisión de moléculas de señalización de patógenos, llevando a una regulación negativa significativa de la expresión de factores de virulencia.
Estudio de caso:
Los ensayos de confrontación en placa mostraron que los oligosacáridos derivados de Enteromorpha a una concentración de 10 mg/mL lograron una tasa de inhibición de hasta el 95.7% contra la fusariosis de la espiga del trigo y hasta el 70.5% contra el mildiu temprano del tomate.
Figura 1 Inhibición de la fusariosis de la espiga del trigo
Figura 2 Inhibición del mildiu temprano del tomate
Los oligosacáridos de algas verdes, con sus únicos mecanismos duales de resistencia a enfermedades, proporcionan una nueva estrategia para la protección verde de cultivos. Sin embargo, los oligosacáridos de algas verdes no modificados presentan inherentemente ciertas limitaciones, incluyendo estabilidad insuficiente, umbrales de actividad altos y capacidad de direccionamiento limitada. Estos desafíos hacen esencial la optimización estructural a través de la ingeniería molecular —un enfoque que se explorará en el próximo artículo: "Modificación estructural y mejora de actividad".
Al modificar con precisión sitios activos como grupos hidroxilo y carboxilo, el Grupo Seawin Biotech está dotando a estas moléculas de origen marino de mayor estabilidad, mejor direccionamiento y mayor eficiencia económica, acelerando su transición desde el laboratorio hasta aplicaciones de campo.
Contexto complementario
Enteromorpha es una alga macroscópica verde perteneciente a la familia Ulvaceae. Es rica en nutrientes beneficiosos para la salud humana y ha sido utilizada durante mucho tiempo como recurso de alga comestible en Asia Oriental. Enteromorpha se caracteriza por su alto contenido de proteína y es abundante en fibra dietética, vitaminas y minerales. Más importante aún, contiene una gama de compuestos bioactivos, incluyendo polisacáridos y polifenoles, que se asocian con posibles beneficios para la salud como actividad antioxidante y modulación de la inmunidad.
Desde el verano de 2008, han ocurrido floraciones a gran escala de Enteromorpha repetidamente en el Mar Amarillo y el Mar de Bohai de China, formando masivas "mareas verdes" que suponen desafíos significativos para los ecosistemas costeros y los paisajes. En este contexto, el Grupo Seawin Biotech, aprovechando las fortalezas científicas de la Universidad Oceánica de China, fue pionero en establecer una cadena industrial completa que abarca la recolección profesional offshore, el procesamiento eficiente onshore y la utilización de alto valor agregado.
A través de tecnologías propias, la empresa convierte Enteromorpha de temporada de floración en materias primas estables y de alta calidad, desarrollándolas además en aditivos para alimentación animal, ingredientes alimentarios, insumos agrícolas y productos biológicos. Este enfoque ha permitido la utilización a gran escala y basada en recursos de Enteromorpha, convirtiendo eficazmente un desafío ambiental en valor económico y ecológico —realizando verdaderamente el Desarrollo Verde y Sostenible.




